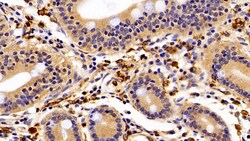

Promotional price valid on web orders only. Your contract pricing may differ. Interested in signing up for a dedicated account number?
Learn More
Learn More
Invitrogen™ IBA1 Polyclonal Antibody
Rabbit Polyclonal Antibody
$155.80 - $416.50
Specifications
| Antigen | IBA1 |
|---|---|
| Concentration | 0.5 mg/mL |
| Content And Storage | Store at 4°C short term. For long term storage, store at -20°C, avoiding freeze/thaw cycles. |
| Applications | Immunohistochemistry (Paraffin), Western Blot |
| Classification | Polyclonal |
| Catalog Number | Mfr. No. | Quantity | Price | Quantity & Availability | |||||
|---|---|---|---|---|---|---|---|---|---|
| Catalog Number | Mfr. No. | Quantity | Price | Quantity & Availability | |||||
|
PIPA5119231
|
Invitrogen™
PA5119231 |
200 μL |
Each for $416.50
|
|
|||||
|
PIPA5121836
|
Invitrogen™
PA5121836 |
20 μL |
Each for $155.80
|
|
|||||
Description
IBA1 Polyclonal Antibody for Western Blot, IHC (P)
Ionized calcium-binding adapter molecule 1 (IBA1), also known by its gene name AIF1, is a protein expressed predominantly by microglia in the brain and spinal cord. This protein belongs to the EF-hand calcium-binding protein family and plays a crucial role in microglial activation and migration in response to brain injury or neuroinflammation. IBA1's function is integral to microglial motility and phagocytic activity, facilitating the cellular response to pathogenic stimuli and promoting tissue homeostasis and repair in the central nervous system. IBA1 serves as a reliable marker for activated microglia in various neurological disorders, including Alzheimer's disease, Parkinson's disease, and multiple sclerosis, where increased expression correlates with disease progression and severity. The protein's structural features enable it to bind calcium ions, inducing conformational changes that activate signaling pathways essential for microglial function. Its expression is highly regulated by inflammatory cytokines, underpinning its role in neuroimmune responses. Due to its specific expression in microglia during pathological conditions, IBA1 is widely used in research as a marker to study microglial status and activity, and it remains a focal point for understanding microglial involvement in neurodegenerative diseases.Specifications
| IBA1 | |
| Store at 4°C short term. For long term storage, store at -20°C, avoiding freeze/thaw cycles. | |
| Polyclonal | |
| Liquid | |
| IgG | |
| Human, Mouse, Pig, Rat | |
| AIF1 | |
| AI607846; AIF1; AIF-1; Allograft inflammatory factor 1; balloon angioplasty responsive transcript; balloon angioplasty-responsive transcript 1; Bart1; BART-1; D17H6S50E; DADB-70P7.8; DASS-82G15.2; Em:AF129756.17; G1; Iba; Iba1; interferon gamma responsive transcript; ionized calcium binding adapter molecule 1; ionized calcium-binding adapter molecule 1; IRT1; IRT-1; microglia response factor; Mrf1; MRF-1; protein BART-1; protein G1; testis specific | |
| AIF1 | |
| Primary | |
| Antigen affinity chromatography, Protein A |
| 0.5 mg/mL | |
| Immunohistochemistry (Paraffin), Western Blot | |
| Unconjugated | |
| Rabbit | |
| RUO | |
| PBS with 50% glycerol and 0.05% ProClin 300; pH 7.4 | |
| O70200, P55008, P55009, P81076 | |
| 11629, 199, 29427, 397271 | |
| Recombinant protein Ionized Calcium-binding Adapter Molecule 1. The antigen corresponds to amino acid range 1-147 of the target protein. | |
| Antibody |
Spot an opportunity for improvement?Share a Content Correction
Product Content Correction
Your input is important to us. Please complete this form to provide feedback related to the content on this product.
Product Title